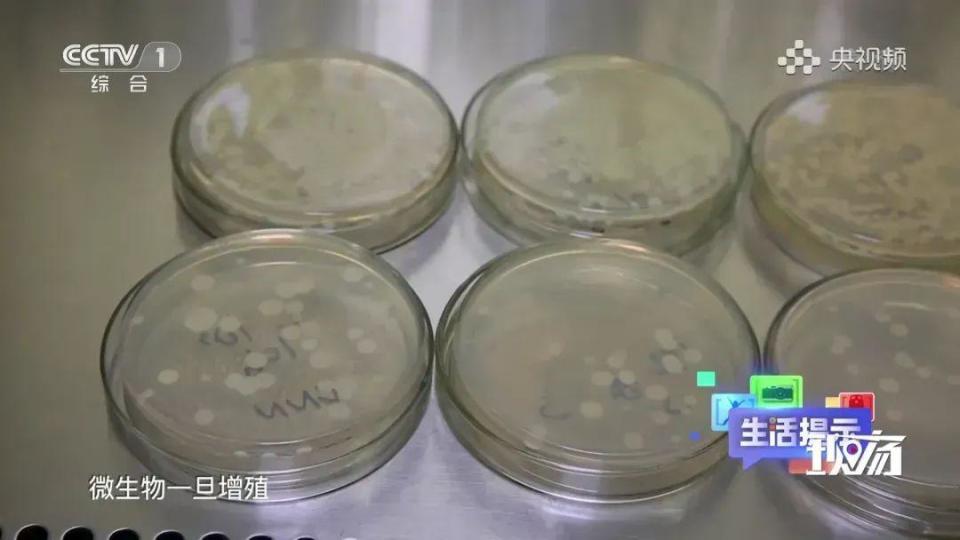
图片

天气越来越冷
不少人换上了保温杯喝热水
但你知道吗?
如果使用不当
养生的保温杯也可能
变身定时“炸弹”
不久前,广东东莞邱先生的儿子用开水洗保温杯,拧紧盖子摇晃了几下,杯子瞬间爆炸,热气腾腾。
邱先生表示,当时自己去取快递不在家,出门前还叮嘱过孩子保温瓶不能用开水去清洗,不能摇晃。回来时事情已经发生了,万幸孩子没有受伤。
对此,不少网友表示,自己其实也不知道保温杯装热水不能摇晃。
其实,保温杯爆炸的原因在于:热水在密封环境下会产生蒸气,摇晃时会使压力增加,导致杯子爆炸。
保温杯里泡红枣枸杞
竟也会引发爆炸?
常言道:保温杯里泡枸杞,疾病来了绕过你。殊不知,保温杯泡枸杞、红枣等养生食材也会引发爆炸!
据报道,四川的杨女士前不久在家准备用餐时,桌上的保温杯突然炸裂,直接将天花板炸出一个洞,当时保温杯中泡的正是枸杞。
图源:新闻晨报
保温杯爆炸并不是偶发事件。此前,福建一名女孩用保温杯泡红枣后忘了喝,直到10多天后才想起要清洗保温杯。当她用力拧开杯盖的一瞬间,杯盖突然崩开砸中了女孩的眼睛,导致其右眼球破裂,血肉模糊。

图源:新闻晨报
实际上,保温杯泡红枣、枸杞发生爆炸是由于微生物发酵产生过多气体所致。保温杯的内胆、瓶盖缝隙等处可能藏匿大量细菌,而红枣、枸杞等食材营养较为丰富,经水浸泡后其中的糖类等成分被溶解出来,更利于微生物繁殖。
在温度适宜、养分充足的环境下,这些微生物会发酵产生大量二氧化碳等气体,且时间越长产生的气体越多。密闭的保温杯内部气压不断增大,一旦杯盖被突然拧开,就可能导致液体喷涌而出,发生爆炸伤人事件。

图源:央视频
这些食物
也最好别放进保温杯
由于保温杯保温功能突出且密封性能较好,很多人不仅用它泡红枣、枸杞,还用来泡茶、装牛奶豆浆等,但其实这些行为存在一定风险。
牛奶、豆浆
牛奶、豆浆等高蛋白饮品最好在灭菌或低温环境下保存。如加热后长时间放置保温杯中,其中的微生物容易迅速繁殖,导致牛奶、豆浆酸败,甚至出现絮状物,饮用后可能引起腹痛、腹泻等肠胃不适症状。
保温杯里装牛奶后迅速繁殖的微生物
茶叶
茶叶富含茶多酚、茶多糖、咖啡因等营养物质,具有较强的保健养生功效。当用茶壶或普通玻璃杯泡茶时,茶叶里的活性及芳香物质会迅速溶出,使得茶香四溢、茶水甘甜。
但用保温杯泡茶相当于持续高温煎煮茶叶,会破坏茶叶中的活性和芳香物质,导致营养流失、茶汤色浓发暗、味道苦涩。
中药
有些人习惯煎好中药后用保温杯装着,一天分几次喝完。但保温杯中温度较高,中药长时间放置容易发生变质,建议放凉后放入冰箱中冷藏保存,等下次要喝时再加热即可。

碳酸饮料和果汁
碳酸饮料、果汁大多呈酸性,若长时间存放在保温杯内,可能会对不锈钢材质产生腐蚀,导致重金属迁移到饮品中。
保温杯清洗不当
可能变成“养菌杯”?
保温杯存在很多卫生死角,比如内胆、瓶盖缝隙、杯口按钮和吸管等,如不及时清洗会导致大量细菌藏匿其中,极易随水入口。因此,应养成定期清洗的好习惯,减少细菌滋生。
在此提醒
刚装上热水的保温杯切勿摇晃
红枣、枸杞等泡水食材
最好现泡现喝
避免长时间浸泡在杯内
来源:新华社微信综合国家应急广播综合新闻晨报、科普中国、健康杭州

